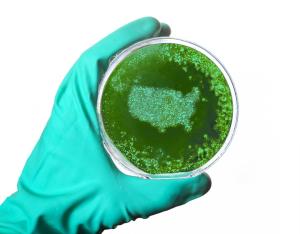
What Is Included in Trump's Plan to Reopen America?

Children in the United States will be able to avoid potentially millions of hours of at-home quarantining under a testing program unveiled by the CDC today.

Children in the United States will be able to avoid potentially millions of hours of at-home quarantining under a testing program unveiled by the CDC today.

The move will offer an extra boost of immunity for patients with compromised immune systems, including organ transplant recipients.

Although news of the delta variant has been front and center, the lambda variant in South America is another strain that public health officials are watching.

The lineage C.37, (Lambda variant), was recently classified as a variant of interest by the World Health Organization (WHO) based on its high circulation rates in South America, and has showed "the ability to escape from neutralizing antibodies elicited by CoronaVac."

A group of scientists who published a letter in a French newspaper asked for an inquiry to determine how the virus emerged.

A discussion with the CDC ’s Flu Czar, Lynnette Brammer, surrounding the upcoming flu season and what we can expect due to the COVID-19 pandemic.

The Centers for Disease Control and Prevention (CDC) weighs in on this topic in light of the new variants.

"Operation Warp Speed" seeks to develop and disburse 100 million doses of a COVID-19 vaccine to the public by year’s end.

Health care settings such as hospitals, clinics, assisted living facilities, and physician offices depend on the circulation of clean air that is free of mold, bacteria, viruses, and fungi.

The first phase allows states to ease lockdowns when they experience a 14-day downward trend in several COVID-19 indicators.

This authorization could replenish the supply of 4 million N95 masks per day.

Published: December 17th 2021 | Updated:

Published: April 14th 2020 | Updated:
Published: April 17th 2020 | Updated:

Published: April 24th 2020 | Updated:

Published: April 30th 2020 | Updated: